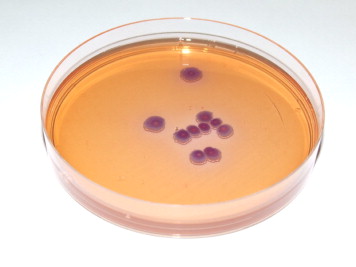
ALIZ-GAL琼脂

ALIZ-GAL琼脂
询价
500ml
起订
上海 更新日期:2026-04-05
产品详情:
- 中文名称:
- ALIZ-GAL琼脂
- 产品类别:
- 培养基
公司简介
上海邦景实业有限公司主要从事免疫学、分子生物学和常规生化试剂的研发、销售。并代理销售Omega、Sigma、R&D、GBD、ATCC、HYCLONE IBL Amresco等二十多家国外知名品牌,致力于为广大高校、科研院所和企事业单位提供一流的科研试剂和完善的技术服务
| 成立日期 | (12年) |
| 注册资本 | 100.000000万人民币 |
| 员工人数 | 10-50人 |
| 年营业额 | ¥ 100万以内 |
| 经营模式 | 试剂,服务 |
| 主营行业 | 生化试剂,抗体 |
ALIZ-GAL琼脂相关厂家报价 更多
-

- Aliz-gal琼脂培养基基础
- 上海冠导生物工程有限公司 VIP
- 2026-04-09
- 询价
-

- ALIZ-GAL琼脂
- 青岛高科技工业园海博生物技术有限公司
- 2026-04-05
- ¥595
-

- Aliz-gal琼脂粉末培养基
- 上海冠导生物工程有限公司 VIP
- 2026-04-09
- 询价
-

- Aliz-gal琼脂干粉培养基
- 上海冠导生物工程有限公司 VIP
- 2026-04-09
- 询价
-

- Aliz-gal琼脂干燥粉末培养基
- 上海冠导生物工程有限公司 VIP
- 2026-04-09
- 询价
-

- Aliz-gal琼脂细粉末培养基
- 上海冠导生物工程有限公司 VIP
- 2026-04-09
- 询价
-

- Aliz-gal琼脂固体粉末培养基
- 上海冠导生物工程有限公司 VIP
- 2026-04-09
- 询价
-

- Aliz-gal琼脂粉末状态培养基
- 上海冠导生物工程有限公司 VIP
- 2026-04-09
- 询价
-

- Aliz-gal琼脂细粉末基础培养基
- 上海冠导生物工程有限公司 VIP
- 2026-04-09
- 询价
-

- Aliz-gal琼脂固体基础培养基
- 上海冠导生物工程有限公司 VIP
- 2026-04-09
- 询价